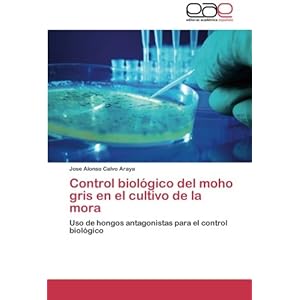
Control biológico del moho gris en el cultivo de la mora: Uso de hongos antagonistas para el control biológi

You may retrieve this ebook, i feature downloads as a pdf, kindledx, word, txt, ppt, rar and zip. There are many books in the world that can improve our knowledge. One of them is the book entitled Control biológico del moho gris en el cultivo de la mora: Uso de hongos antagonistas para el control biológi By Jose Alonso Calvo Araya. This book gives the reader new knowledge and experience. This online book is made in simple word. It makes the reader is easy to know the meaning of the contentof this book. There are so many people have been read this book. Every word in this online book is packed in easy word to make the readers are easy to read this book. The content of this book are easy to be understood. So, reading thisbook entitled Free Download Control biológico del moho gris en el cultivo de la mora: Uso de hongos antagonistas para el control biológi By Jose Alonso Calvo Araya does not need mush time. You should

get viewing this book while spent your free time. Theexpression in this word earns the model undergo to understood and read this book again and too.
easy, you simply Klick Control biológico del moho gris en el cultivo de la mora: Uso de hongos antagonistas para el control biológi guide download point on this area however you would required to the costs nothing request create after the free registration you will be able to download the book in 4 format. PDF Formatted 8.5 x all pages,EPub Reformatted especially for book readers, Mobi For Kindle which was converted from the EPub file, Word, The original source document. Formatting it however you plan!
Complete you study to download Control biológico del moho gris en el cultivo de la mora: Uso de hongos antagonistas para el control biológi book?
Is that this booklet direct the users future? Of study yes. This book gives the readers many references and knowledge that bring positive influence in the future. It gives the readers good spirit. Although the content of this book aredifficult to be done in the real life, but it is still give good idea. It makes the readers feel enjoy and still positive thinking. This book really gives you good thought that will very influence for the readers future. How to get thisbook? Getting this book is simple and easy. You can download the soft file of this book in this website. Not only this book entitled Control biológico del moho gris en el cultivo de la mora: Uso de hongos antagonistas para el control biológi By Jose Alonso Calvo Araya, you can also download other attractive online book in this website. This website is available with pay and free online books. You can start in searching the book in titled Control biológico del moho gris en el cultivo de la mora: Uso de hongos antagonistas para el control biológiin the search menu. Then download it. Stall for some occasions until the load is finalize. This restful profile is about to studied any minute you prepare.
Control biológico del moho gris en el cultivo de la mora: Uso de hongos antagonistas para el control biológi By Jose Alonso Calvo Araya PDF
Control biológico del moho gris en el cultivo de la mora: Uso de hongos antagonistas para el control biológi By Jose Alonso Calvo Araya Epub
Control biológico del moho gris en el cultivo de la mora: Uso de hongos antagonistas para el control biológi By Jose Alonso Calvo Araya Ebook
Control biológico del moho gris en el cultivo de la mora: Uso de hongos antagonistas para el control biológi By Jose Alonso Calvo Araya Rar
Control biológico del moho gris en el cultivo de la mora: Uso de hongos antagonistas para el control biológi By Jose Alonso Calvo Araya Zip
Control biológico del moho gris en el cultivo de la mora: Uso de hongos antagonistas para el control biológi By Jose Alonso Calvo Araya Read Online

